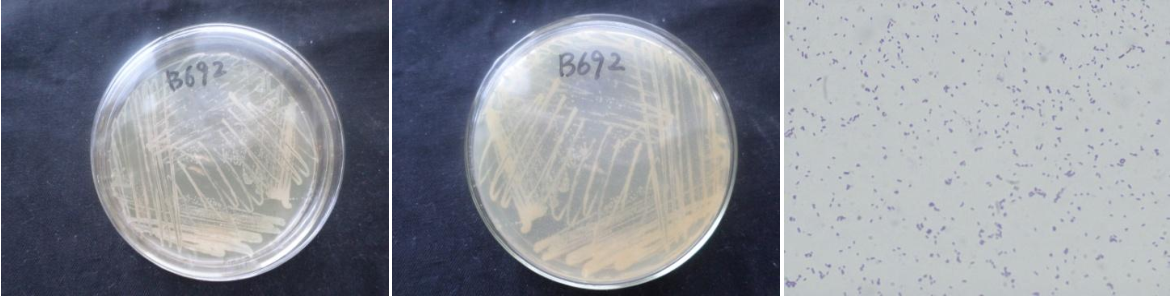

Loading...
| StrainNO | B692 |
| Classification | Halomonas |
| 16s rDNA sequence | CATGCAGTCGAGCGGCAGCACGGGGAGCTTGCTCCCTGGTGGCGAGCGGCGGACGGGTGAGTAATGCATAGGAATCTGCCCGGT AGTGGGGGATAACCTGGGGAAACCCAGGCTAATACCGCATACGTCCTACGGGGGAAAGCGGGGGCTCTTCGGACCTCGCGCTAT CGGATGAGCCTATGTCGGATTAGCTGGTTGGTGAGGTAACGGCTCACCAAGGCGACGATCCGTAGCTGGTCTGAGAGGATGATC AGCCACATCGGGACTGAGACACGGCCCGAACTCCTACGGGAGGCAGCAGTGGGGAATATTGGACAATGGGGGCAACCCTGATCC AGCCATGCCGCGTGTGTGAAGAAGGCCTTCGGGTTGTAAAGCACTTTCAGTGGGGAAGAAAGCCTTCCGGCCAATACCCGGGAG GAAGGACATCACCCACAGAAGAAGCACCGGCTAACTCCGTGCCAGCAGCCGCGGTAATACGGAGGGTGCGAGCGTTAATCGGAA TTACTGGGCGTAAAGCGCGCGTAGGTGGCTTGATAAGCCGGTTGTGAAAGCCCCGGGCTCAACCTGGGAACGGCATCCGGAACT GTCAGGCTAGAGTGCAGGAGAGGAAGGTAGAATTCCCGGTGTAGCGGTGAAATGCGTAGAGATCGGGAGGAATACCAGTGGCGA AGGCGGCCTTCTGGACTGACACTGACACTGAGGTGCGAAAGCGTGGGTAGCAAACAGGATTAGATACCCTGGTAGTCCACGCCG TAAACGATGTCGACTAGCCGTTGGGTCCTTCGCGGACTTTGTGGCGCAGTTAACGCGATAAGTCGACCGCCTGGGGAGTACGGC CGCAAGGTTAAAACTCAAATGAATTGACGGGGGCCCGCACAAGCGGTGGAGCATGTGGTTTAATTCGATGCAACGCGAAGAACC TTACCTACCCTTGACATCCTCGGAATCCGCCGGAGACGGCGGAGTGCCTTCGGGAGCCGAGTGACAGGTGCTGCATGGCTGTCG TCAGCTCGTGTTGTGAAATGTTGGGTTAAGTCCCGTAACGAGCGCAACCCTTGTCCCTATTTGCCAGCGATTCGGTCGGGAACT CTAGGGAGACTGCCGGTGACAAACCGGAGGAAGGTGGGGACGACGTCAAGTCATCATGGCCCTTACGGGTAGGGCTACACACGT GCTACAATGGTTGGTACAAAGGGTTGCGAACTTGCGAAAGTGAGCTAATCCCAGAAAGCCGATCTCAGTCCGGATCGGAGTCTG CAACTCGACTCCGTGAAGTCGGAATCGCTAGTAATCGTGAATCAGAATGTCACGGTGAATACGTTCCCGGGCCTTGTACACACC GCCCGTCACACCATGGGAGTGGACTGCACCAGAAGTGGTTAGCCTAACCTTCGGGAGGGCGATCACCACGGTGTGGTTCATGAC TGGGGTGAAG |
| Strain Morphology Photos | |
| Morphological Description | Colony round;soybean milk yellow;edge neatly;steam bun shaped;slippy;sticky;Wax Sample;Bacteriophage Rod-shaped;no spore |